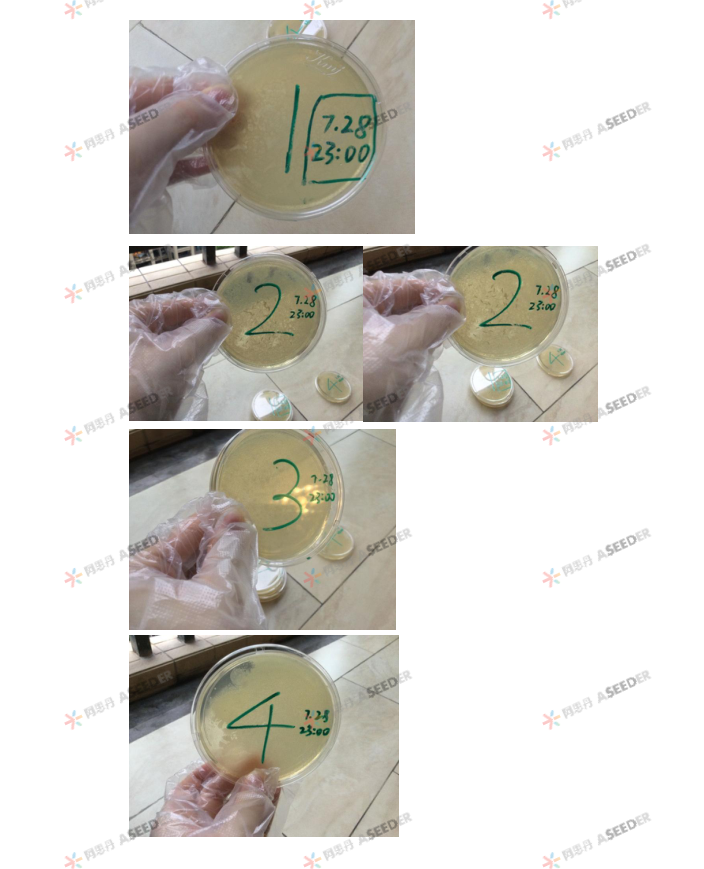
ASDAN EPQ数学/化学方向高分选题盘点

EPQ对海外本科申请优势的硬核提升让“申英人手一个EPQ”的观念深入人心,学生不仅能在此收获独立研究能力提升,还能获得UCAS加分、名校条件性录取优势、文书面试优质话题,为大学申请增添亮眼砝码。
然而,如何选择一个符合学术要求的选题,往往是学生面临的第一个难题。为此,我们特别整理了EPQ高分选题合集系列,从多个学科领域出发,为学生提供切实可行的选题参考。
本期聚焦 👉🏻数学 / 化学方向
统计学
概率问题
应用数学
化学制剂
化学材料
产品配方
涵盖数学、化学、材料学等热门领域,帮助学生找到选题灵感,建议收藏!后续我们还将推出其他理工类方向、社科、人文等学科的选题合集,敬请期待
👉🏻商科方向高分选题合集
👉🏻物理方向高分选题合集
如果你正在准备做EPQ,不妨从这篇推文开始!
⌛10秒了解EPQ
EPQ (Extended Project Qualification)是英国教育部和高等教育招生服务中心(UCAS)强烈推荐的研究性学习认证项目,是一门不需要考试的课程。
ASDAN EPQ要求同学在老师指导下选择一个自己感兴趣的课题进行研究性学习,然后将学习的过程和研究成果汇总成一篇接近5000字的英文文章,或1000字的英文文章加上一个可展示项目(用于发明、创作等),最后进行15分钟的答辩。经过评审后,最终同学可获得EPQ证书、评级与最高UCAS 28学分加分。
数学/化学方向选题热门话题

整理自10个批次的高分选题
选题合集 - 论文形式




选题合集 - 可展示作品形式
可展示作品(Artefact)是ASDAN EPQ特有的成果形式,在已有的案例中,同学们的Artefact种类包括商业计划书、科学发明、编程、服装设计、建筑设计、编舞、表演、纪录片、插画、绘本等,ASDAN EPQ接受更多成果形式!
对数学专业的学生来说,最常选择的是应用数学,即将数学/统计学理论应用于日常活动,如设计游戏、优化活动流程等。化学专业的同学更多选择研究日常生活中的化学制剂或化学材料,如可降解环保材料、日化产品配方等。
由于该过程涉及文献阅读、线上与线下调研、数据分析、复盘等严谨的过程,ASDAN EPQ接受其作为一种达到研究性学习质量的成果,在评估成绩时与论文形式成果的标准一致。
《设计一个棋盘游戏,帮助学生复习A-LEVEL中的数学应用整合课程》
EPQ成绩:A*
2024年春季学期


《气凝胶在深水游泳衣中的潜在用途》
EPQ成绩:A
2022春季学期


《设计一种日常材料的康乃馨保鲜剂》
EPQ成绩:A
2021春季学期

沉浸式EPQ tour
已经有灵感了?马上带你沉浸式体验EPQ!
思维发散/ Step 1
同学们将在老师的带领下从申请专业、日常兴趣、热门话题等角度挖掘可研究的选题。几乎所有受访EPQer都建议学弟学妹:一定要选一个感兴趣的选题!









阿思丹独家科研理论课/ Step 2
ASDAN EPQ由EPQ全球考纲命题专家带领,研发并汉化教学内容,共涵盖了从入门学习至写作提交的9大章节内容,确保适龄学员能够理解EPQ考纲、个人时间管理、科学研究方法、数据处理、学术英文写作及英语学术答辩等要领;
并编纂中文学员用书、提供实用型录播微课及理论课录屏,供学员随时查阅复习、巩固研究基石。
现在报名,立即开始理论课!
中外导师2对1辅导/ Step 3
ASDAN EPQ充分采用源于14世纪牛津大学的牛剑式导师制辅导模式,导师制自发源以来广泛传播到世界各地高校,现在仍是牛剑名校重要的教学模式之一。在该辅导模式下,学生将匹配平均教龄20年的资深英方学术导师兼考官(SA),与导师每周进行约1小时的学术讨论,内容包括学术知识指导、科研问题讨论、个性化答疑、思维启发等。
此外,学生还将匹配一位考试局认证的资深中方学术导师(TA),全程辅助教学。
成果提交 收获成绩/ Step 4
选择论文作为成果形式的同学将提交5000字左右的英文论文和EPQ表格;选择可展示作品为成果形式的同学将提交作品、1000字英文报告和EPQ表格。
现在报名参加2025年秋季学期,明年3月提交,预估成绩可以用于秋季申请!
